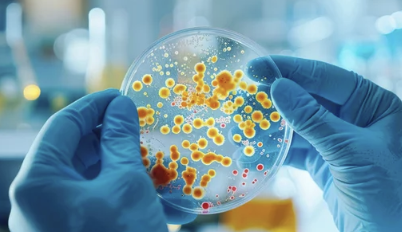

๋ชฉ์ด ๋ถ๊ณ ์ํ ๋ ์์ธ๊ณผ ๋์ฒ๋ฒ ์๋ฒฝ ์ ๋ฆฌ
- ์นดํ ๊ณ ๋ฆฌ ์์
- 2024. 8. 16. 13:36
๐ฃ ๋ชฉ์ด ๋ถ๊ณ ์ํ ๋, ํน์ ๋๋? ์์ธ๊ณผ ๋์ฒ๋ฒ ์๋ฒฝ ์ ๋ฆฌ ๐ฃ
๊ฐ์๊ธฐ ๋ชฉ์ด ๋ถ๊ณ ๋ฐ๋๊ฑฐ๋ฆฌ๋ ํต์ฆ์ด ๋๊ปด์ง ์ ์์ผ์ ๊ฐ์? ์นจ ์ผํค๊ธฐ๋ ํ๋ค๊ณ ํน์ ํฐ ๋ณ์ ์๋๊น ๊ฑฑ์ ๋์์ฃ ? ๋ชฉ ํต์ฆ๊ณผ ๋ถ๊ธฐ๋ ํํ๊ฒ ๊ฒช๋ ์ฆ์์ด์ง๋ง, ๋๋ก๋ ์ฌ๊ฐํ ์งํ์ ์ ํธ์ผ ์๋ ์์ต๋๋ค. ์ค๋์ ๋ชฉ์ด ๋ถ๊ณ ์ํ ๋ ์์ฌํด ๋ณผ ์ ์๋ ๋ค์ํ ์์ธ๊ณผ ์ฆ์, ๊ทธ๋ฆฌ๊ณ ํจ๊ณผ์ ์ธ ๋์ฒ๋ฒ๊น์ง ๊ผผ๊ผผํ๊ฒ ์๋ ค๋๋ฆด๊ฒ์! ๐
1. ๋ชฉ ํต์ฆ๊ณผ ๋ถ๊ธฐ, ์ ๋ฐ์ํ ๊น์? ๐ค

๋ชฉ ํต์ฆ๊ณผ ๋ถ๊ธฐ๋ ๋ค์ํ ์์ธ์ ์ํด ๋ฐ์ํ ์ ์์ต๋๋ค. ๊ฐ์ฅ ํํ ์์ธ์ ๊ฐ๊ธฐ๋ ์ธํ์ผ๊ณผ ๊ฐ์ ๊ฐ์ผ์ฑ ์งํ์ด์ง๋ง, ์๋ ๋ฅด๊ธฐ, ์ญ๋ฅ์ฑ ์๋์ผ, ๊ฐ์์ ์งํ ๋ฑ ๋ค๋ฅธ ์์ธ์ผ ๊ฐ๋ฅ์ฑ๋ ์์ต๋๋ค.
- ๊ฐ์ผ: ๋ฐ์ด๋ฌ์ค๋ ์ธ๊ท ๊ฐ์ผ์ผ๋ก ์ธํด ๋ชฉ ์์ชฝ ์ ๋ง์ ์ผ์ฆ์ด ์๊ธฐ๋ฉด ๋ชฉ์ด ๋ถ๊ณ ์ํ ์ฆ์์ด ๋ํ๋ ์ ์์ต๋๋ค. ๊ฐ๊ธฐ, ์ธํ์ผ, ํธ๋์ผ ๋ฑ์ด ๋ํ์ ์ธ ๊ฐ์ผ์ฑ ์งํ์ ๋๋ค.
- ์๋ ๋ฅด๊ธฐ: ๊ฝ๊ฐ๋ฃจ, ๋จผ์ง, ์์ ๋ฑ ์๋ ๋ฅด๊ธฐ ์ ๋ฐ ๋ฌผ์ง์ ๋ ธ์ถ๋๋ฉด ๋ชฉ ์์ชฝ์ด ๋ถ๊ณ ๊ฐ๋ ค์์ฆ์ ๋๋ฐํ ํต์ฆ์ด ๋ฐ์ํ ์ ์์ต๋๋ค.
- ์ญ๋ฅ์ฑ ์๋์ผ: ์์ฐ์ด ์๋๋ก ์ญ๋ฅํ๋ฉด์ ๋ชฉ ์์ชฝ ์ ๋ง์ ์๊ทนํ์ฌ ์ผ์ฆ๊ณผ ํต์ฆ์ ์ ๋ฐํ ์ ์์ต๋๋ค. ๋ชฉ์ ์ด๋ฌผ๊ฐ์ด ๋๊ปด์ง๊ฑฐ๋ ์ฐ ๋ชฉ์๋ฆฌ๊ฐ ๋๋ ๊ฒฝ์ฐ๋ ์์ต๋๋ค.
- ๊ฐ์์ ์งํ: ๊ฐ์์ ๊ธฐ๋ฅ ํญ์ง์ฆ์ด๋ ๊ฐ์์ ์ผ ๋ฑ ๊ฐ์์ ์งํ์ผ๋ก ์ธํด ๋ชฉ์ด ๋ถ๊ณ ํต์ฆ์ด ๋ฐ์ํ ์ ์์ต๋๋ค.
- ์คํธ๋ ์ค: ์คํธ๋ ์ค๋ ๋ฉด์ญ๋ ฅ์ ์ ํ์ํค๊ณ ๊ทผ์ก ๊ธด์ฅ์ ์ ๋ฐํ์ฌ ๋ชฉ ํต์ฆ์ ์ ํ์ํฌ ์ ์์ต๋๋ค.
- ๊ณผ๋ํ ๋ชฉ ์ฌ์ฉ: ํฐ ์๋ฆฌ๋ก ๋งํ๊ฑฐ๋ ๋ ธ๋๋ฅผ ๋ถ๋ฅด๋ ๋ฑ ๋ชฉ์ ๊ณผ๋ํ๊ฒ ์ฌ์ฉํ๋ฉด ๋ชฉ ๊ทผ์ก์ ๋ฌด๋ฆฌ๊ฐ ๊ฐํด์ ธ ํต์ฆ์ด ๋ฐ์ํ ์ ์์ต๋๋ค.
- ์๋ชป๋ ์์ธ: ์ฅ์๊ฐ ์ปดํจํฐ ์ฌ์ฉ, ์ค๋งํธํฐ ์ฌ์ฉ ๋ฑ์ผ๋ก ์ธํด ๋ชฉ์ ์์ผ๋ก ์ญ ๋นผ๋ ์์ธ๋ฅผ ์ ์งํ๋ฉด ๋ชฉ ๊ทผ์ก์ ๋ถ๋ด์ ์ฃผ๊ณ ํต์ฆ์ ์ ๋ฐํ ์ ์์ต๋๋ค.
2. ๋ชฉ์ด ๋ถ๊ณ ์ํ ๋, ์ด๋ค ์ฆ์๋ค์ด ๋ํ๋ ๊น์? ๐



- ๋ชฉ ํต์ฆ: ๋ชฉ ์์ชฝ์ด ๋ฐ๋๊ฑฐ๋ฆฌ๊ฑฐ๋ ์นผ์นผํ ๋๋, ์นจ ์ผํฌ ๋ ํต์ฆ, ๋ชฉ์๋ฆฌ ๋ณํ ๋ฑ์ด ๋ํ๋ ์ ์์ต๋๋ค.
- ๋ชฉ ๋ถ๊ธฐ: ๋ชฉ ์์ชฝ์ด๋ ์์ชฝ์ด ๋ถ๊ณ ๋ง์ก์ ๋ ํต์ฆ์ด ๋๊ปด์ง ์ ์์ต๋๋ค.
- ๋ฐ์ด: ๊ฐ์ผ์ฑ ์งํ์ธ ๊ฒฝ์ฐ ๋ฐ์ด์ด ๋๋ฐ๋ ์ ์์ต๋๋ค.
- ์ฝง๋ฌผ, ์ฝ๋งํ: ๊ฐ๊ธฐ๋ ์๋ ๋ฅด๊ธฐ ๋น์ผ์ด ์์ธ์ธ ๊ฒฝ์ฐ ์ฝง๋ฌผ์ด๋ ์ฝ๋งํ ์ฆ์์ด ํจ๊ป ๋ํ๋ ์ ์์ต๋๋ค.
- ๊ธฐ์นจ: ๋ชฉ์ ์ผ์ฆ์ด๋ ์ด๋ฌผ๊ฐ์ผ๋ก ์ธํด ๊ธฐ์นจ์ด ๋ฐ์ํ ์ ์์ต๋๋ค.
- ๋ํต: ๋ชฉ ํต์ฆ์ด ์ฌํ ๊ฒฝ์ฐ ๋ํต์ ๋๋ฐํ๊ธฐ๋ ํฉ๋๋ค.
- ํผ๋ก๊ฐ: ๋ฉด์ญ๋ ฅ ์ ํ๋ ์ผ์ฆ์ผ๋ก ์ธํด ํผ๋ก๊ฐ์ ๋๋ ์ ์์ต๋๋ค.
3. ๋ชฉ ํต์ฆ๊ณผ ๋ถ๊ธฐ, ์ด๋ด ๋ ๊ผญ ๋ณ์์ ๊ฐ์ธ์! ๐จ



- ๊ณ ์ด (38.5๋ ์ด์)
- ์ฌํ ํต์ฆ: ์นจ ์ผํค๊ธฐ ์ด๋ ต๊ฑฐ๋ ์จ์ฌ๊ธฐ ํ๋ ๊ฒฝ์ฐ
- ๋ชฉ ๋ถ์์ ํน์ด๋ ๋ฉ์ธ์ด ๋ง์ ธ์ง๋ ๊ฒฝ์ฐ
- ์ฆ์์ด 1์ฃผ์ผ ์ด์ ์ง์๋๋ ๊ฒฝ์ฐ
- ์ฐ ๋ชฉ์๋ฆฌ, ๊ท ํต์ฆ, ํผ๋ถ ๋ฐ์ง ๋ฑ ๋ค๋ฅธ ์ฆ์์ด ๋๋ฐ๋๋ ๊ฒฝ์ฐ
4. ๋ชฉ ํต์ฆ ์ํ, ์ํ ์ ์์ ์ต๊ด๋ถํฐ! ๐



- ์ถฉ๋ถํ ํด์: ๋ชธ์ด ํ๋ณตํ ์ ์๋๋ก ์ถฉ๋ถํ ํด์์ ์ทจํ๋ ๊ฒ์ด ์ค์ํฉ๋๋ค.
- ์๋ถ ์ญ์ทจ: ๋ฐ๋ปํ ๋ฌผ์ด๋ ์ฐจ๋ฅผ ์์ฃผ ๋ง์ ๋ชฉ์ ์ด์ดํ๊ฒ ์ ์งํ๊ณ ์ผ์ฆ ์ํ์ ๋์์ ์ค๋๋ค.
- ๊ฐ์ต: ๊ฑด์กฐํ ํ๊ฒฝ์ ๋ชฉ ํต์ฆ์ ์ ํ์ํฌ ์ ์์ต๋๋ค. ๊ฐ์ต๊ธฐ๋ฅผ ์ฌ์ฉํ๊ฑฐ๋ ์ ์ ์๊ฑด์ ๊ฑธ์ด ์ค๋ด ์ต๋๋ฅผ ์กฐ์ ํด์ฃผ์ธ์.
- ๋ฐ๋ปํ ์ฐ์ง: ๋ฐ๋ปํ ๋ฌผ์๊ฑด์ด๋ ์ฐ์งํฉ์ผ๋ก ๋ชฉ์ ์ฐ์งํ๋ฉด ํ์ก์ํ์ ์ด์งํ๊ณ ํต์ฆ์ ์ํํ๋ ๋ฐ ๋์์ด ๋ฉ๋๋ค.
- ์๊ธ๋ฌผ ๊ฐ๊ธ: ๋ฐ๋ปํ ๋ฌผ์ ์๊ธ์ ๋ น์ฌ ๊ฐ๊ธํ๋ฉด ๋ชฉ ์์ชฝ ์ผ์ฆ ์ํ์ ์ด๊ท ํจ๊ณผ๋ฅผ ๊ธฐ๋ํ ์ ์์ต๋๋ค.
- ๊ธ์ฐ & ์ ์ฃผ: ํก์ฐ๊ณผ ์์ฃผ๋ ๋ชฉ ๊ฑด๊ฐ์ ์ ์ํฅ์ ๋ฏธ์น๋ฏ๋ก ํผํ๋ ๊ฒ์ด ์ข์ต๋๋ค.
- ๋ชฉ ์คํธ๋ ์นญ: ํํ์ด ๋ชฉ ์คํธ๋ ์นญ์ ํ์ฌ ๋ชฉ ๊ทผ์ก ๊ธด์ฅ์ ํ์ด์ฃผ๊ณ ํต์ฆ์ ์ํํ ์ ์์ต๋๋ค.
5. ๋ชฉ ํต์ฆ ์ํ์ ๋์ ๋๋ ์์๋ค ๐ฏ



- ๋ฐ๋ปํ ์ฐจ: ์๊ฐ์ฐจ, ๋ ๋ชฌ์ฐจ, ๊ฟ์ฐจ ๋ฑ ๋ฐ๋ปํ ์ฐจ๋ ๋ชฉ์ ๋ถ๋๋ฝ๊ฒ ํ๊ณ ์ผ์ฆ ์ํ์ ๋์์ด ๋ฉ๋๋ค.
- ๋ฐ๋ปํ ์ฃฝ: ๋ถ๋๋ฌ์ด ์ฃฝ์ ๋ชฉ์ ์๊ทน์ ์ฃผ์ง ์๊ณ ์์์ ๊ณต๊ธํ์ฌ ํ๋ณต์ ๋์์ด ๋ฉ๋๋ค.
- ๊ฟ: ๊ฟ์ ํญ๊ท ๋ฐ ํญ์ผ ํจ๊ณผ๊ฐ ์์ด ๋ชฉ ํต์ฆ ์ํ์ ์ข์ต๋๋ค. ๋ฐ๋ปํ ๋ฌผ์ ๊ฟ์ ํ์ ๋ง์๊ฑฐ๋ ๊ฟ์ ๋ฃ์ ์ฐจ๋ฅผ ๋ง์ ๋ณด์ธ์.
- ๋นํ๋ฏผ C: ๋นํ๋ฏผ C๋ ๋ฉด์ญ๋ ฅ ๊ฐํ์ ๋์์ ์ฃผ์ด ๊ฐ์ผ ์๋ฐฉ ๋ฐ ์น๋ฃ์ ํจ๊ณผ์ ์ ๋๋ค. ๊ทค, ์ค๋ ์ง, ํค์ ๋ฑ ๋นํ๋ฏผ C๊ฐ ํ๋ถํ ๊ณผ์ผ์ ์ญ์ทจํ์ธ์.
6. ์ต๊ทผ ์ฐ๊ตฌ ๊ฒฐ๊ณผ, '์ด๊ฒ' ๋ชฉ ๊ฑด๊ฐ์ ํจ๊ณผ์ ! ๐ฑ
- ํ๋กํด๋ฆฌ์ค: ์ต๊ทผ ์ฐ๊ตฌ์ ๋ฐ๋ฅด๋ฉด, ํ๋กํด๋ฆฌ์ค๋ ํญ๊ท , ํญ์ผ, ํญ์ฐํ ํจ๊ณผ๊ฐ ๋ฐ์ด๋ ๋ชฉ ์ผ์ฆ ์ํ์ ๋ฉด์ญ๋ ฅ ๊ฐํ์ ๋์์ด ๋๋ค๋ ๊ฒฐ๊ณผ๊ฐ ๋ฐํ๋์์ต๋๋ค. ํ๋กํด๋ฆฌ์ค ์คํ๋ ์ด๋ ์บ๋๋ฅผ ํ์ฉํด ๋ณด์ธ์.
7. ๋ชฉ ๊ฑด๊ฐ, ํ์ ๊ด๋ฆฌ๊ฐ ์ค์ํฉ๋๋ค! ๐



๋ชฉ ํต์ฆ๊ณผ ๋ถ๊ธฐ๋ฅผ ์๋ฐฉํ๊ธฐ ์ํด์๋ ํ์ ์ํ ์ต๊ด ๊ฐ์ ์ด ์ค์ํฉ๋๋ค.
- ์ ์์ฃผ ์ป๊ธฐ: ์์ ํตํด ์ธ๊ท ์ด๋ ๋ฐ์ด๋ฌ์ค๊ฐ ์ ํ๋ ์ ์์ผ๋ฏ๋ก, ์ธ์ถ ํ๋ ์์ฌ ์ ํ ๋ฑ ๊นจ๋ํ๊ฒ ์์ ์ป๋ ์ต๊ด์ ๋ค์ด์ธ์.
- ๋ง์คํฌ ์ฐฉ์ฉ: ๋ฏธ์ธ๋จผ์ง๋ ๊ฐ์ผ ์๋ฐฉ์ ์ํด ์ธ์ถ ์ ๋ง์คํฌ๋ฅผ ์ฐฉ์ฉํ๋ ๊ฒ์ด ์ข์ต๋๋ค.
- ์ค๋ด ํ๊ธฐ: ์พ์ ํ ์ค๋ด ํ๊ฒฝ์ ์ ์งํ๊ธฐ ์ํด ์์ฃผ ํ๊ธฐ๋ฅผ ์์ผ์ฃผ์ธ์.
- ์ถฉ๋ถํ ์๋ฉด: ๋ฉด์ญ๋ ฅ ๊ฐํ๋ฅผ ์ํด ์ถฉ๋ถํ ์๋ฉด์ ์ทจํ๋ ๊ฒ์ด ์ค์ํฉ๋๋ค.
- ์คํธ๋ ์ค ๊ด๋ฆฌ: ์คํธ๋ ์ค๋ ๋ฉด์ญ๋ ฅ์ ์ ํ์ํค๊ณ ๋ชฉ ํต์ฆ์ ์ ํ์ํฌ ์ ์์ต๋๋ค. ๋ช ์, ์๊ฐ, ์ทจ๋ฏธ ํ๋ ๋ฑ์ ํตํด ์คํธ๋ ์ค๋ฅผ ๊ด๋ฆฌํ๋ ๊ฒ์ด ์ค์ํฉ๋๋ค.
๋ง๋ฌด๋ฆฌํ๋ฉฐ
๋ชฉ ํต์ฆ๊ณผ ๋ถ๊ธฐ๋ ์ผ์์ํ์ ํฐ ๋ถํธ์ ์ด๋ํ ์ ์์ต๋๋ค. ํ์ง๋ง ์ค๋ ์๋ ค๋๋ฆฐ ๋ฐฉ๋ฒ๋ค์ ํตํด ๊พธ์คํ ๊ด๋ฆฌํ๋ฉด ์ถฉ๋ถํ ๊ฐ์ ํ ์ ์์ต๋๋ค. ๐
์ฐธ๊ณ ์๋ฃ
- ๋ํ์ด๋น์ธํ๊ณผํํ: https://www.korl.or.kr/
- ๊ฑด๊ฐ๋ณดํ์ฌ์ฌํ๊ฐ์: https://www.hira.or.kr/
์ด ๊ธ์ ์ ๋ณด ์ ๊ณต์ ๋ชฉ์ ์ผ๋ก ์์ฑ๋์์ผ๋ฉฐ, ์ํ์ ์ง๋จ์ด๋ ์น๋ฃ๋ฅผ ๋์ ํ ์ ์์ต๋๋ค. ์ฆ์์ด ์ง์๋๊ฑฐ๋ ์ ํ๋ ๊ฒฝ์ฐ ๋ฐ๋์ ์ง์ ๋ณ์์์ ์ง๋ฃ๋ฅผ ๋ฐ์ผ์๊ธธ ๋ฐ๋๋๋ค.